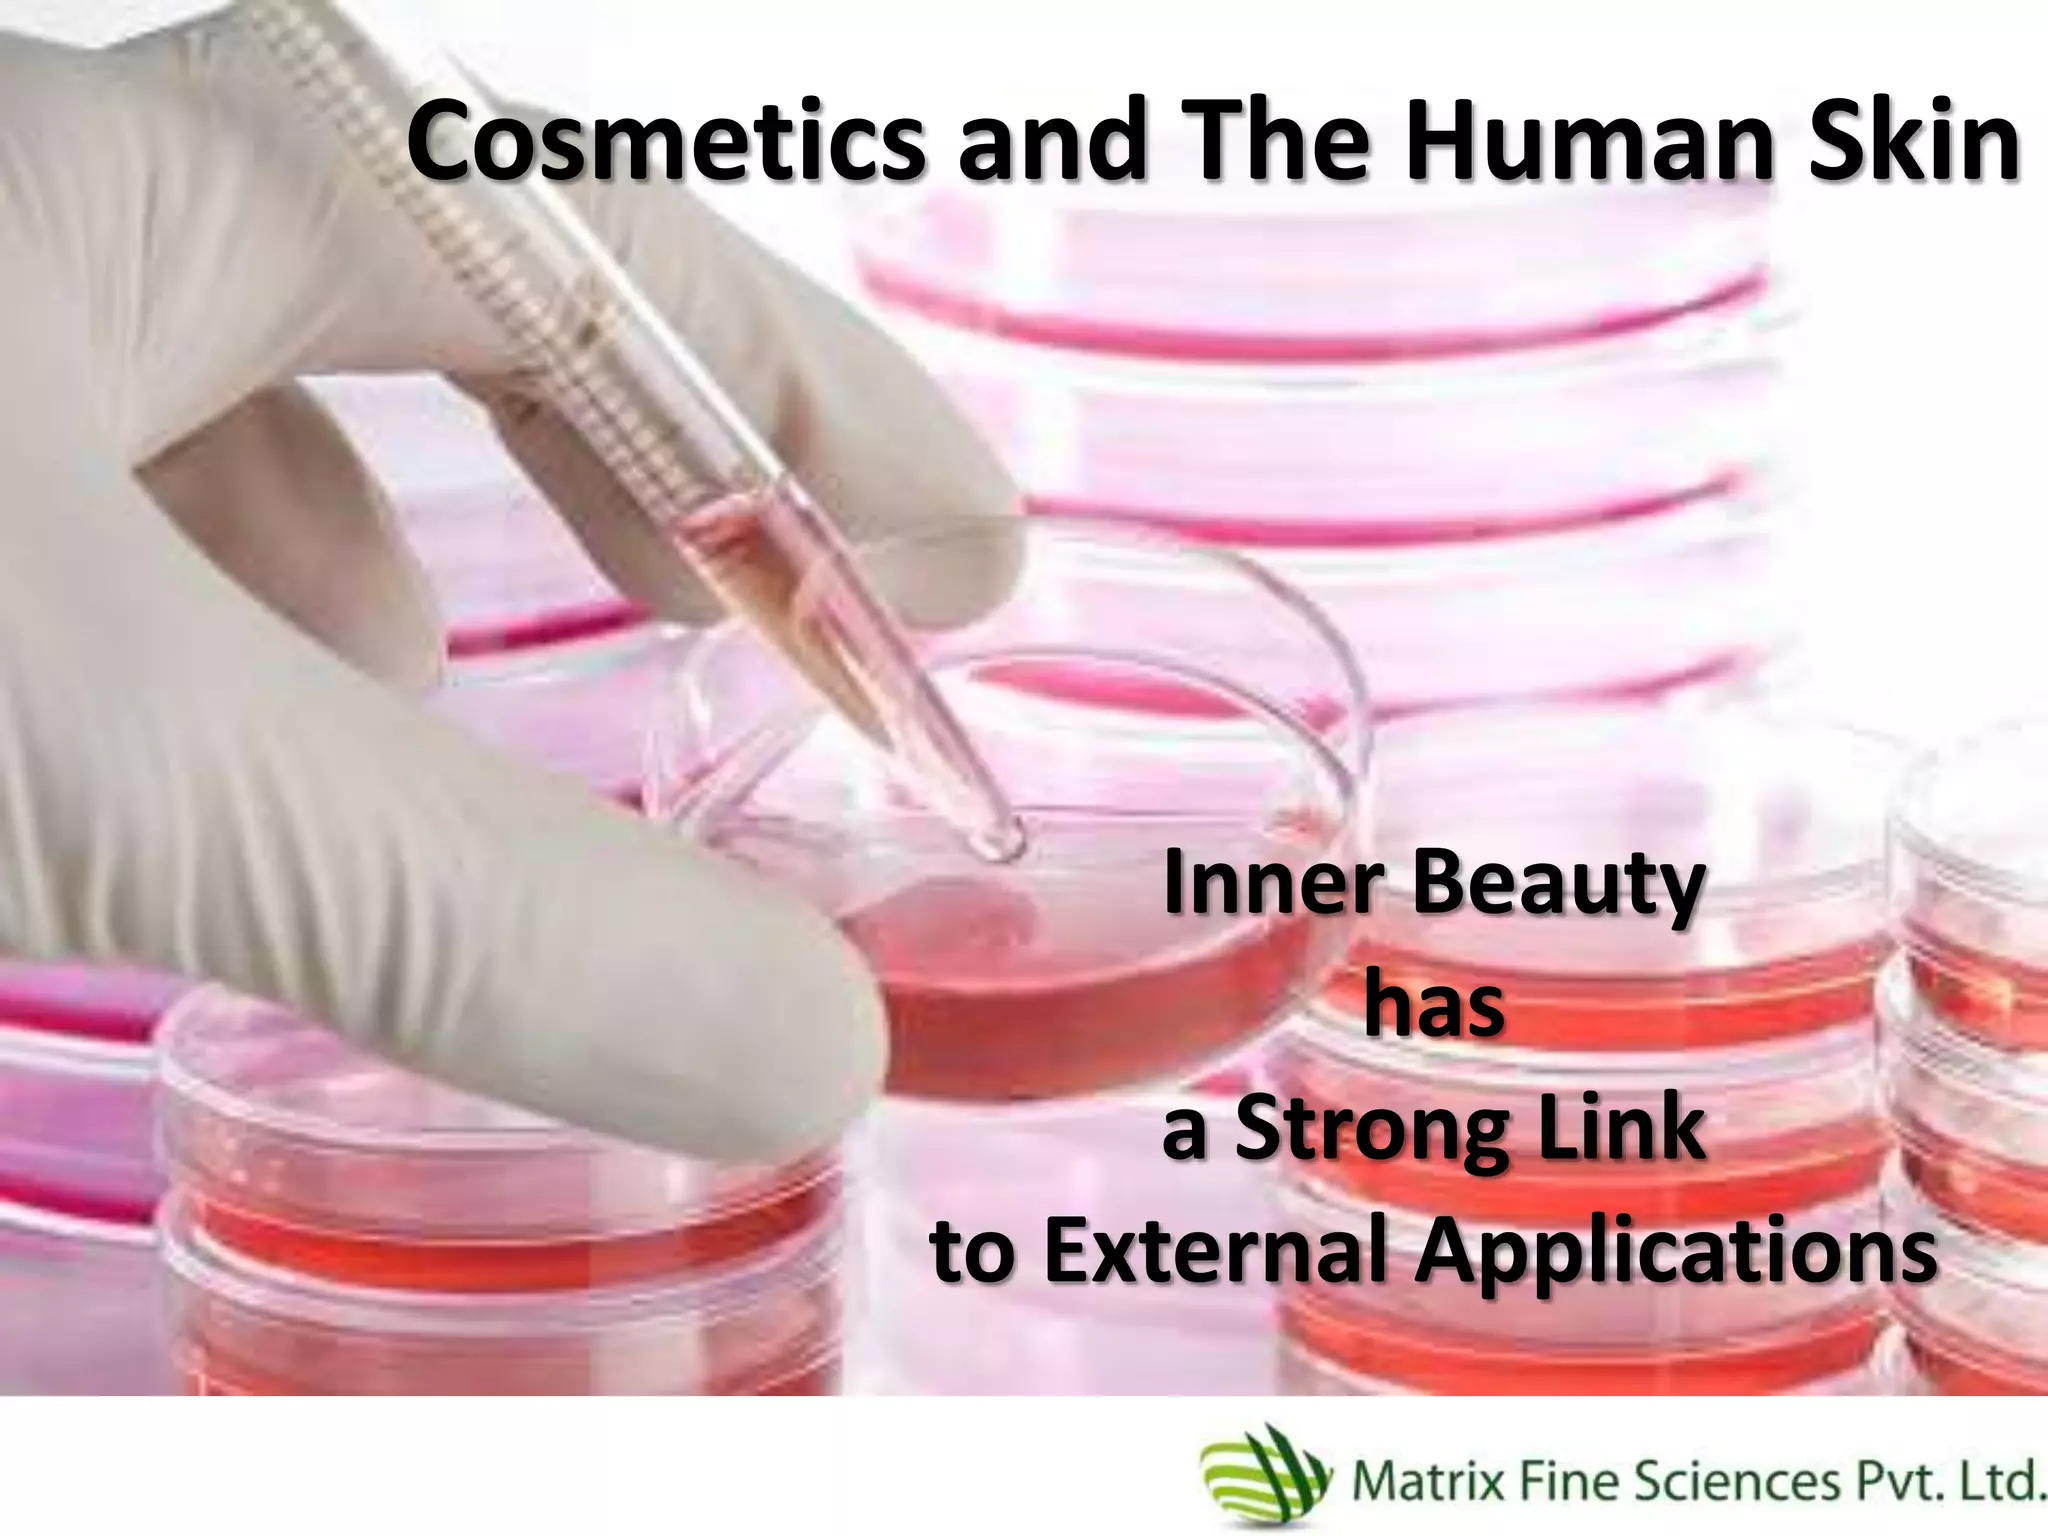
Cosmetics and The Human Skin
Inner Beauty
has
a Strong Link
to External Applications

Matrix Fine Sciences Pvt Ltd specializes in manufacturing natural mixed tocopherols, a form of Vitamin E, which provides numerous benefits for skin health and cosmetics, such as antioxidant properties, moisture retention, and protection against photoaging and pollutants. The document highlights the superiority of natural Vitamin E over synthetic variants in terms of efficacy and skin compatibility while emphasizing the company's commitment to natural and environmentally friendly production methods. Additionally, it outlines various applications of Vitamin E in cosmetics and health-related products, underscoring its role as an effective ingredient for skincare and hair care.